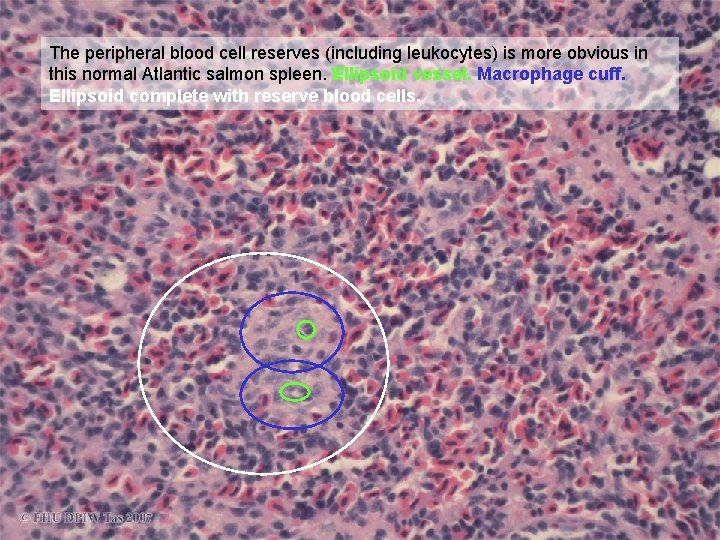
The peripheral blood cell reserves (including leukocytes) is more obvious in this normal Atlantic

Systematic Fish Pathology Part 5 Spleen Prepared by

Systematic Fish Pathology: Part 5. Spleen Prepared by Judith Handlinger Fish Health Unit, Animal Health Laboratory, Department of Primary Industries & Water, Tasmania for The Australian Animal Pathology Standards (AAPSP) Program

Before Entering Training Program READ ME • • This series of training modules has been prepared from a teaching slide set used for short courses on fish histopathology aimed at students with a range of prior knowledge of either pathology or fish. Slides are representative of the pathology found in Australian fish in this (Tasmanian) fish laboratory, rather than a comprehensive record of all fish diseases, or diseases of all fish. There are some examples from other laboratories, including exotic diseases. The major aim is to convey an approach to diagnosis, not to cover all fish diseases. The systematic approach is relevant, regardless of species (indeed this is just applying mammalian pathology training to fish). Nevertheless the pathology of any species can only be interpreted in comparison with the known normal. As there are more fish species than all the other vertebrates together, it is necessary to overcome the temptation to consider fish just a new “species” for study, and appreciate the diversity of fish species. That this course does not cover all Australian fish, then, is within the context of using available material to impart a general knowledge of fish pathology including general patterns of fish diseases and an introduction to types of pathogen common in fish.

Acknowledgments. • • • Most material used has largely been generated within the Tasmanian Department of Primary Industries & Environment Fish Health Unit, and represents contribution of cases and photographs from many other contributors including Jeremy Carson, David Taylor, Stephen Pyecroft, Richmond Loh, Kevin Ellard, Paul Hardy-Smith, and Barry Munday. Contributors of cases from other laboratories have been acknowledged wherever possible and specific material and photographs used with permission. Any inadvertent omissions in this regard are unintended. Material exotic to Australia includes slides distributed for general teaching purposes and slides contributed specifically for the DPIW Fish Teaching set, and are acknowledged as such.

Introduction to the spleen • Please refer to Part I “Consider the Fish” for an introduction to fish anatomy, histology and immunology, and how and why these differ from terrestrial animals, and Parts 2 - 4 on the kidney, for an introduction to host response cells and their reactions. These also introduce the major groups of fish pathogens. • The kidney was chosen for the introduction of fish reactions as this is a major site of haematopoiesis and a major reticulo-endothelial & macrophage filtration bed. The spleen is the other major organ with these functions. • The reticuloendothelial / macrophage function of the spleen is organised round the splenic ellipsoid vessels. • The exact haematopoietic role varies between species from an apparently secondary role in many species, to the only haematopoietic organ in some fish such as the perch, Perca fluviatilis, and the main site of erythropoiesis in rainbow trout. • The lymphoid tissue has a simpler organisation than in higher vertebrates, but can be differentiated into periarterial lymphatic sheaths and periellipsoid sheaths, where other haematopoietic cells may also be found. • Spleen pathology reflects these functions.

Spleen presentation outline • Spleen anatomy • Functional microanatomy • Recognising basic generalised spleen reactions: – of the ellipsoid – peri-arterial lymphoid reactions – the interstitial areas (“red pulp”) • Destruction / necrosis in the ellipsoids complexes. • Pigmentation and the spleen • Focal reactions and disturbances of architecture.

Spleen Anatomy The spleen is closely associated with the intestine and pancreas. (This spleen is somewhat enlarged)

Typical teleost spleen (Goldfish). The spleen develops from a fold in the developing intestinal wall, so is closely associated with the intestine and pancreas. Spleen Intestine Pancreas Liver Sp-1 x 4 o

Spleen anomaly: this Atlantic salmon spleen has developed within the pancreas, showing the close the relationship between these organs during development. Sp 11 x 4 o

Micro-anatomy & histology Visualising the architecture and reactions of : – A. the ellipsoids – B. lymphoid tissue (“white pulp”) – C. interstitial blood channels (“red pulp”)

Functional micro-anatomy 1 Visualising the architecture and reactions of : – A. the ellipsoids – B. lymphoid tissue (“white pulp”) – C. interstitial blood channels (“red pulp”)

Micro-anatomy - ellipsoids overview • • • The key anatomical feature differentiating the spleen is the ellipsoid, specialised thick walled but fenestrated terminal arterioles surrounded by a periarteriolar sheath of macrophages and reticular cells. Part of the blood passes via these fenestrations through this cuff of macrophages, which recognise and remove effete red cells and foreign material as they pass through this zone. The cells which pass this gauntlet collect in the interstitial areas (the “red pulp”) and gradually re-enter the blood stream. The rest of the blood passes flows directly from the terminal arterioles to the interstitial red pulp and thence to the venules. The other major features of the typical spleen are lymphoid-rich areas along the major arteries, and less well defined areas of haematopoiesis and storage of blood cell reserves. The latter typically form an outer zone to the ellipsoids, as a darker rim to the macrophage zone. As in the kidney, macrophage activity results in the formation of melano-macrophages, which may aggregate into melanomacrophage-centres (MM centres), though they aggregate poorly in salmonids which are again used as a demonstration species. Remember these melanomacrophages contain end products such as phospholipids and variety of residual pigments that may include true melanin (typically black), haemosiderin, ceroid, or lipofuscin (yellow-pink to golden brown), in vacuoles. This process also results in very effective re-cycling of iron from effete erythrocytes.

Near normal though congested spleen of a Goldfish with Aeromonas hydrophila infection. Even at low magnification (x 4 objective), the spleen shows a regular architecture, from irregular pigmented areas. of the architecture Apart fromapart the pigmented areas, the key features are prominent thick walled vessels, round to elliptical in section (and therefore called ellipsoids). Some of these arrowed. Pigment Spleen Intestine Pancreas Liver Sp-1 x 4 o

Higher magnification shows the pigmented areas to be melano-macrophage centres. The ellipsoids are thick walled terminal arterioles lined by fenestrated endothelia and surrounded by a cuff of macrophages and reticular cells. The macrophage cuffs of these ellipsoids are active (A. Hydrophila infection), and the passage of blood cells through the cuff can be clearly seen. What these ellipsoids lack is a well defined peripheral cuff of mature leukocytes, which normally comprise a significant proportion of the available leukocyte Sp- 1 x 20 o
The peripheral blood cell reserves (including leukocytes) is more obvious in this normal Atlantic salmon spleen. Ellipsoid vessel. Macrophage cuff. Ellipsoid complete with reserve blood cells. S 2 x 20 o

This Gram stained section of a spleen from an acute overwhelming experimental infection with Lactococcus garvieae (previously known as an Enterococcus seriolicida or “Strep”), shows the ellipsoid macrophages outlined by the large numbers of Gram positive bacteria they contain. ( x 10 objective). This number of bacterial would not be expected during natural infections. The bacteria under oil emersion 4 a x 100 o 4 a x 10 o

Overview (x 4 objective) of this slide showing the ellipsoid distribution pattern. Note cells other than active macrophages line the major vessels (e. g lymphoid “white pulp” areas). 4 a x 4 o

Same block. In fact there are so many bacteria in this spleen that they are readily visible on a heavily stained H&E stain, occupying most of the ellipsoid complex. Note too the marked interstitial congestion and The bacteria aredepletion. surrounding the capillary, virtually replacing the peripheral ellipsoid reticular-macrophage cuff. (This number of bacteria reflects an excessive experimental dose, and would be a most unusual appearance in natural infections, but they do illustrate the architecture. ) S 4 Sx 10 o 4 x 40 o S 4 x 4

Microanatomy 2 • Visualising the architecture: – A. the ellipsoids – B. lymphoid tissue (“white pulp”) & other haematopoietic tissue – C. interstitial blood channels (“red pulp”)

Microanatomy - lymphoid tissue overview • • • The lymphoid tissue of the fish spleen has a simpler organisation than in higher vertebrates (there are no lymphoid nodules), but can still be a useful indicator of the magnitude and nature of immune reactions: the clues mean the same as in higher vertebrates – there are just less of them in fish. The most obvious lymphoid tissue in the spleen is often peri-arterial lymphoid sheaths, though these may be small or inapparent in fish not undergoing a response. Lymphoid tissue also forms a fine layer round ellipsoid cuffs and melanomacrophage centres. Plasma cells can sometimes be found in large numbers in this site also. It is interesting that photos from Petterson et al, 2000, using monoclonal antibodies against salmon Ig. M (eg) on cryostat sections demonstrate B-cells in the salmon spleen, apparently at the margins of some ellipsoids, but not in lymphocytes in a periarterial cuff – suggesting that, as in higher vertebrates, these periarterial sheaths are T-cell dependent areas, whereas peri-ellipsoid lymphoid tissue is B-cell dependent. – – – Pettersen, EF, R. Bjerknes, R and H. I. Wergeland (2000). Studies of Atlantic salmon (Salmo salar L. ) blood, spleen and head kidney leucocytes using specific monoclonal antibodies, immunohistochemistry and flow cytometry. Fish & Shellfish Immunology 10, 695– 710. Available online at http: //www. idealibrary. com on Ideal® For illustrations for analogous lymphoid organisation in mammals see Press and Landsverk, The Immune System In Dellmann’s Textbook of Veterinary Histology, 6 th Ed (Eurell J & Frappies B eds), Blackwell publishing, 2006 ; and for avians see Cross, GM (1987). The Lymphatic System. In Proceedings of the workshop on avian histpathology, Australian Veterinary Poultry Association, Camden, Feb, 1987.

The presence of the peripheral cuff makes the ellipsoid vessel less obvious in larger spleens at low power (x 4 objective), though the ellipsoid basis of the architecture can still be appreciated. S 2 x 4

At slightly higher magnification: Note the specific “white pulp” areas of lymphoid response S 2 x 10 o

This salmon shows a more generalized peri-arterial lymphoid proliferation. S 10 x 4 o

This young salmon (recently vaccinated and moved to sea, where more new antigens would be encountered), shows a generalised peri-ellipsoid lymphoid proliferation (though no doubt this also contains other cell types). S (081304 -12 S)(081304 -12 x)20 x 10 ) x 4

Microanatomy 3 • Visualising the architecture: – A. the ellipsoids – B. lymphoid tissue (“white pulp”) – C. interstitial blood channels (“red pulp”)

Micro-anatomy - interstitial areas • Blood cells passing out of the vessels through the fenestrated ellipsoid vessels accumulate between the ellipsoids (“red pulp”, though this term is rarely used in fish), and gradually flow back to the venous system. • Not all the blood flows through the ellipsoid wall, some passing directly through the capillaries to the venous system

Slight congestion makes the interstitial “red pulp” areas ( ) more obvious in this otherwise “normal” (inactive) Atlantic salmon spleen. Note the peripheral reserve blood cell cuff which is quite obvious in this example. Ellipsoid vessel. Macrophage cuff. Ellipsoid complete with reserve blood cells. S-ex x 20

This salmon shows – normal ellipsoids But more obvious, paler and apparently more structured interstitial “red pulp” areas Ex x 4

This salmon spleen also shows normal ellipsoids (although there has a recently been some interstitial congestion, with some residual interstitial reaction which we will examine later). Note the size of ellipsoids and the relative thickness of the macrophage cuff. Ex x 10

Microanatomy 4 - other species • Spleen structure is similar in other teleost species. • General species differences recap: (see - PPT II-1 V) – the degree of aggregation of effete macrophages (containing pigmented residual material of various forms) varies between species and is usually stronger than in salmonids. – The distribution of haematopoietic activity between spleen and kidney also varies with species, with the spleen being the major site of erythropoietic activity in many species.

Low power view of a normal Striped Trumpeter spleen. Like the Goldfish above, melanomacrophage centres are more obvious but Ellipsoids. contain overall paler pigment mixture than in salmonids. Melanomacrophage centres, Note erythrocytes passing through the ellipsoid cuff x 40 o x ST 10 ox 4 o

Striped trumpeter spleen, example 2. This is a much younger fish. Note the more prominent lymphoid / haematopoietic areas round vessels and some ellipsoids. x 4 o x 10 o x 4 o

Basic generalised spleen reactions Recognising the reactions of: – the ellipsoid – peri-arterial lymphoid tissue – the interstitial areas (“red pulp”)

Ellipsoid reactions 1. The function of ellipsoids and nature of reactions

Note the overall size of the ellipsoids of this relatively normal salmonid spleen (x 10 objective) S 2 x 10 o

How, then, should these larger, paler ellipsoids be interpreted? This is a Rainbow trout (so-called - but that is actually just another salmon species with same general spleen morphology. ) Same magnification. S 3 x 10 o

At higher magnification, the ellipsoid vessel(s) can be clearly seen ( surrounded by a much larger cuff of pale cells. ), The macrophage nature of these cells is implied by the melanin-like residual pigment in many of these. Note too that there are very few darker peripheral cells. S 3 x 40

Ellipsoid reactions - overview This is a spleen from a natural (more long-standing) case of L. garvieae infection and illustrates two types of ellipsoid reaction: • the macrophage zone is markedly enlarged, compared to the normal spleen. • the ellipsoids shown also lack the usual rim of mature leucocytes These key changes reflect the functional physiology of these units: • typically the mature cells (along with those stored in the kidney) are to a greater or lesser extent mobilised into the blood stream as response to anoxia (red cells), or infection (leukocytes), or stress (both). Often the response is relatively non-specific, so it is not uncommon to find both an increase in red cells and a leukocytosis. • Increased blood flow and increased debris or foreign material passing through the ellipsoid will increase phagocytic activity and lead to recruitment of more macrophages, but may also damage these cells. We will now explore some ellipsoid reactions to bacteria (or similar insults).

Ellipsoid reactions 2 Early reactions: • Mobilisation of mature reserve blood cells (seen as depletion of peripheral ellipsoid cuffs) • Congestion (increased blood flow). Both are a response to increase the number of leukocytes (particularly polymorphs) available for response, and increase oxygen availability. This is a typical general reaction to stress, not just to infection. Note that circulating lymphocytes, however are depressed by stress. Summary reference: Barton, BA & Iwama, GK, 1991. Physiological Changes in Fish from Stress in Aquaculture with Emphasis on the Response and Effects of Corticosteroids. Annual Review of fish Diseases 1: 3 -26.

An Atlantic salmon spleen showing an acute reaction following an (unidentified) stress: Note the lack of dark peripheral mature cells round the macrophage cuff, at as well as the obvious congested interstitial areas. x 4 o

Another example of ellipsoids with very depleted peripheral cuffs (and congestion). Stressed salmon. S 072181 -4 x 10 o x 4 o
- Slides: 40